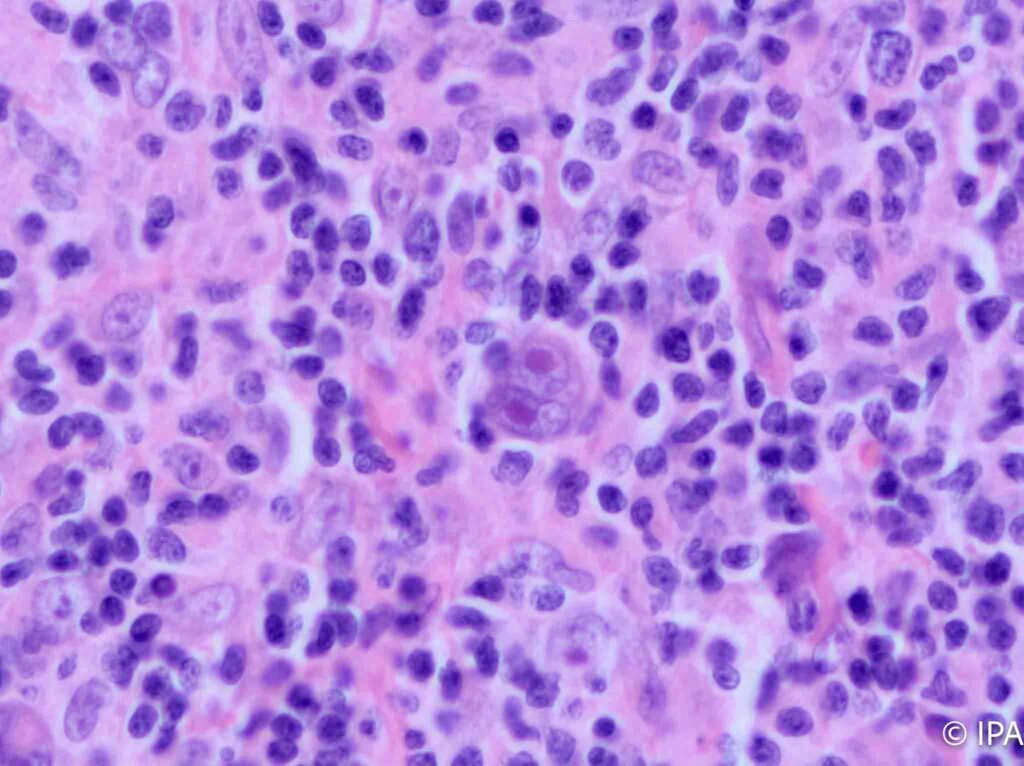

En el IPA, el diagnóstico no se limita a la observación microscópica; se trata de una integración de hallazgos morfológicos, fenotípicos y moleculares. Nuestras áreas de actividad se estructuran en unidades de alta especialidad:
🔬 Unidades de Patología Quirúrgica y Oncológica
El núcleo de nuestra actividad, enfocado en la estadificación precisa y la determinación de factores pronósticos y predictivos.
- Dermatopatología avanzada: Diagnóstico diferencial de lesiones melanocíticas complejas y control de márgenes en cirugía micrográfica.
- Patología del Aparato Digestivo: Especialización en enfermedad inflamatoria intestinal y cribado oncológico colorrectal.
- Patología Mamaria y Ginecológica: Evaluación exhaustiva de biopsias de vacío (BVA) y piezas quirúrgicas, con integración de receptores y biomarcadores, patología cervical, valoración del endometrio en la infertilidad.
- Uropatología: Estudio detallado de próstata, vejiga y patología renal no tumoral. Patología testicular.
- Hematopatología y Partes Blandas: Diagnóstico de linfomas y sarcomas de alta complejidad.
- Patología de cabeza y cuello: Tiroides y paratiroides, laringe, glándula salival, tumores de cabeza y cuello.
- Patología oncológica: Estudio y cuantificación de biomarcadores, inestabilidad de microsatélites, alteraciones genómicas.
🧪 Citopatología de Alta Resolución
Procesamiento y lectura de muestras citológicas con un enfoque clínico-patológico.
- Citología Exfoliativa: Programas de cribado cérvico-vaginal (Triple toma clásica y base líquida).
- Punción Aspiración con Aguja Fina (PAAF): Diagnóstico inmediato de nódulos tiroideos, glándulas salivales y linfoadenopatías.
- Citología de Líquidos y Serosas: Análisis de derrames pleurales, ascíticos y orinas con protocolos de enriquecimiento celular.
🧬 Laboratorio de Técnicas Especiales y Molecular
La tecnología al servicio de la medicina personalizada.
- Inmunohistoquímica (IHC) Automatizada: Acceso a panel de más de 100 anticuerpos para la caracterización de tumores de origen desconocido y perfiles moleculares subrogados.
- Patología Molecular: Coordinación de estudios de hibridación in situ (FISH) y determinación de mutaciones críticas para terapias dirigidas.
- Diagnóstico Intraoperatorio: Evaluación por congelación en tiempo real para la toma de decisiones críticas en quirófano.
🖥️ División de Patología Digital y Segunda Opinión
- Digitalización de Casos (WSI): Transformación de la muestra física en datos digitales para análisis computacional.
- Consultoría de Segunda Opinión: Servicio de revisión de casos externos para pacientes y facultativos que requieran la validación de un experto con 40 años de trayectoria.
Impacto en la Gestión y Calidad
Trazabilidad Absoluta: Cada muestra es monitorizada mediante un sistema de identificación por código de barras, eliminando cualquier riesgo de error preanalítico.
Compromiso Temporal:
- Biopsia Estándar: 24-72 horas.
- Biopsia Compleja: Sujeta a técnicas complementarias, con informe preliminar inmediato.
- Citología: < 48 horas.
Contacto
Laboratorio del Instituto de Patología (IPA) en el hospital Vithas Perpetuo Socorro Internacional
📞 +34 965 144 061
Laboratorio del Instituto de Patología (IPA) en el hospital Vithas Medimar Internacional
📞+34 902 298 299 (ext 8071)
